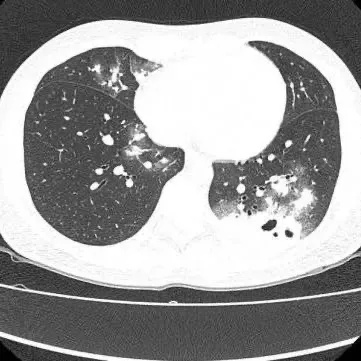
发现1例,阳性!初期或无症状 发现1例,阳性!初期或无症状

近日广州30岁的夏女士(化名)
因持续干咳一周到医院就诊
胸部CT显示其双肺多发感染
伴多发空洞形成
被收入呼吸与危重医学科住院治疗
医生查房时,捕捉到CT上形似“鬼脸”的特殊影像(即“鬼脸征”),并伴有“晕轮征”,高度怀疑隐球菌肺炎。医生追问夏女士近期是否曾接触鸟类、禽类及饲养宠物,夏女士否认。

医生安排夏女士抽血送检,次日,血液及肺泡灌洗液均回报隐球菌抗原阳性,tNGS检出高序列新型隐球菌,夏女士确诊为新型隐球菌肺炎。
得知这个诊断,夏女士回忆起来,两周前她收到朋友送的两只鸽子,她把鸽子圈养在家四天,后续宰杀鸽子煲汤服用,这是确切的接触史。医生考虑感染新型隐球菌与宰杀鸽子相关。夏女士经过规范治疗后,顺利康复出院。
认识这个“伪装大师”
隐球菌肺炎
医生介绍,新型隐球菌是广泛存在于鸽粪、土壤及腐烂植物中真菌,干燥后形成气溶胶颗粒,通过呼吸道吸入感染人体。
高危人群为:养鸽人、鸟类爱好者、园艺工作者等长期接触鸟类或土壤者及免疫力低下者(HIV、器官移植、长期使用激素)。
医生表示,隐球菌肺炎初期可无症状,轻症表现类似感冒(咳嗽、低热、胸痛),易被忽视。
进展风险:重症可能出现高热、呼吸困难、咯血等症状。若隐球菌肺炎未及时控制,约10%患者会并发脑膜炎,隐球菌脑膜炎死亡率高达60%-80%,若出现持续头痛、恶心呕吐,需立即就诊。
在影像学表现方面,典型CT表现是单发/多发结节伴“晕轮征”,结节液化坏死可形成空洞形似“鬼脸征”,空洞常为薄壁空洞、无液平。
莫慌!治疗有方
遵医嘱实行抗真菌治疗
该医院医生提醒,感染新型隐球菌,遵医嘱实行抗真菌治疗。需密切门诊随诊,足疗程抗感染,切勿自行停药。早诊早治是关键,及时治疗可完全吸收肺内病灶,避免后遗症。在预防方面,请注意:
养鸟人群:
每日清理鸟笼(戴N95口罩+橡胶手套)。鸟笼放置通风处,避免卧室摆放。接触后彻底洗手,衣物及时清洗。
高风险活动:
避免在鸽群聚集处长时间停留,翻土种植时做好口鼻防护,不接触野生禽类粪便。
健康监测:
若出现持续咳嗽、胸痛、发热,尤其有鸟类接触史者,需主动告知医生,排查隐球菌感染。
医生提醒
近年来
隐球菌肺炎发病率上升3倍!
如果持续咳嗽超过2周
抗生素治疗无效时
务必进行隐球菌抗原筛查
早期诊断可避免发生
致死性的隐球菌脑膜炎
转自:广州日报
点击右上角
微信好友
朋友圈

点击浏览器下方“
”分享微信好友Safari浏览器请点击“
”按钮

点击右上角
QQ

点击浏览器下方“
”分享QQ好友Safari浏览器请点击“
”按钮
